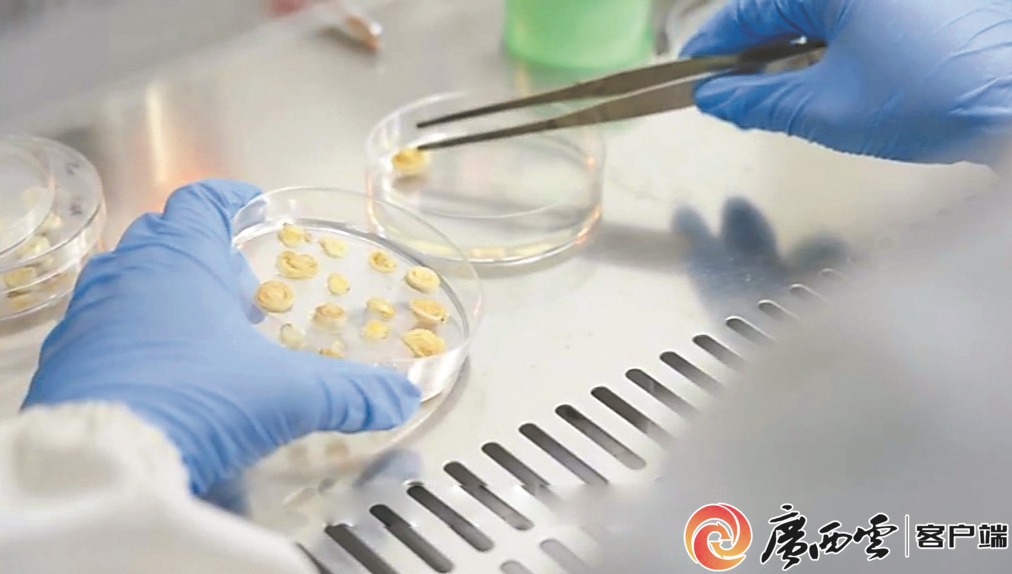

http://www.gxnews.com.cn/staticpages/20250328/newgx67e5ecab-21775284.shtml



新聞眼
科技創新浪潮奔涌,新質生產力正成為區域競爭的關鍵變量。今年全國兩會期間,習近平總書記強調,科技創新和產業創新,是發展新質生產力的基本路徑。廣西以“新春第一會”擂響戰鼓,直面“有何硬核技術”“缺什么”“抓什么”的時代之問,探尋差異化突圍路徑。
當前,八桂大地上,新能源汽車、新材料、新能源等新產業、新業態加速崛起;與此同時,創新生態、成果轉化、要素集聚等環節的現實瓶頸也愈發凸顯。如何抓住新一輪科技革命和產業變革機遇?如何將區位優勢轉化為創新勝勢?廣西云-廣西日報調研組深入區內外產學研一線,探究創新鏈與產業鏈無縫對接之道,解鎖“實驗室”到“生產線”的轉化密碼。
調研視頻。攝制:廣西云-廣西日報記者 付瑋燁
《中國區域科技創新評價報告2024》顯示,2024年廣西綜合科技創新水平指數為51.79%,比上年提高了2.5個百分點,增幅高于全國平均水平1.2個百分點,排全國第22位、西部地區第5位。
負重爬坡的廣西,雖然暫時落后,但正發力趕超:全社會研發投入經費從2019年的167.13億元增加到2023年的228.15億元,增長了36.5%,其中企業研究與試驗發展經費支出占全區總量的比重連續6年提高,達到79.8%,高于全國平均水平(77.7%)2.1個百分點;高新技術企業突破4100家,形成創新矩陣;新備案專利產品增長74%,新產業新產品對工業增長貢獻率超50%,戰略性新興產業貢獻率超32%,見證“智造”升級。
弄潮兒向濤頭立。“新一輪科技革命浪潮洶涌澎湃,厘清創新資源,找準關鍵癥結,是廣西科技創新變道超車需要認真思考的問題。”中國科學院研究員、廣西科學院人工智能研究院院長黃廷磊說。
“首字號”硬核,何以能?
自治區科技廳對全區科技創新案例進行盤點,梳理出10大在全國乃至全世界可稱為“首字號”的科技創新成果——
平陸運河集團有限公司全球首創“三最”(世界最大的內河省水船閘、世界最高水頭的省水船閘、世界運行速度最快的省水船閘);廣西南南鋁加工有限公司成功開發半導體級6061鋁合金產品,成為國內目前唯一量產且被廣泛應用在蝕刻機、薄膜沉積設備、離子注入機的產品;桂林藍宇航空輪胎發展有限公司建成并投產我國首條民航輪胎生產線;上汽通用五菱汽車股份有限公司建成全球首個“無人島”精益智造工廠;廣西大學公布首個最完整的現代甘蔗栽培種基因組序列;廣西能源集團有限公司成功實施全國首個全嵌巖基礎海上風電項目;廣西柳工機械股份有限公司研制出國內首臺(套)重大技術裝備-870HE磷礦上料工況無人駕駛電動裝載機;桂林電子科技大學等研制出國內首條稀土熔鹽電解自動化生產線,鞏固了我國稀土工業在國際的地位;桂林萊茵生物科技股份有限公司建成國內首條甜菊糖生物合成生產線;廣西大學榮獲我區首個華夏建設科學技術獎一等獎。

由桂林藍宇航空輪胎發展有限公司自主研制的中國首條民用航空子午線輪胎裝配空客A320飛機,并在桂林兩江機場試飛成功,實現了我國民用航空子午線輪胎零的突破。何平江 攝

防城港海上風電示范項目A場址鳥瞰。廣西能源集團供圖
硬核技術,對地方經濟競爭力的提升、區域創新生態構建、地方發展品牌塑造,甚至國家經濟安全與韌性等,都起到關鍵作用。
廣西這些硬核技術和應用,何以能領跑全國乃至全世界?“一系列成果不是天上掉下來的,這是廣西科技創新和產業創新長期積累、不斷融合孕育出來的果實。”自治區科技廳相關負責人說。
一、資源稟賦是科技創新的起跳板
廣西“家底”豐厚,有優良的生態、豐富的自然資源、獨特的區位優勢,以及經過多年發展積累的產業基礎。科技創新不是無本之木,它來自于發展的需求,也服務于發展的需求。創新的方向、突破的賽道,就藏在廣西的資源稟賦和產業圖譜中。
仔細分析10個“首字號”科技成果發現,它們絕大部分根植于廣西獨特的資源優勢。例如,現代甘蔗栽培種基因組序列研究成果的取得,正是立足于廣西糖料蔗種植面積和產量全國第一的基礎。
科研人員在實驗室進行甘蔗基因研究。(資料圖片)
廣西大學首次解析我國自育高抗黑穗病高產高糖甘蔗新品種——中蔗1號染色體水平的全基因組序列,定位了1個黑穗病抗性相關區域,這是迄今為止最完整的現代甘蔗栽培種基因組序列,為進一步解析甘蔗重要農藝性狀的分子機制奠定了基礎。有了這些高水平科技創新成果的加持,廣西成為全國有名的“糖罐子”。
又如,廣西是全國著名的有色金屬之鄉,擁有豐富的鋁土礦資源,儲量位居全國第3,占中國資源儲量1/3以上。如何點“鋁”成金?南南鋁加工錨定有色金屬資源稟賦,深耕細分領域,通過技術賦能,實現價值指數級裂變。
圍繞前沿鋁新材料應用問題,南南鋁加工與航空工業制造院、各航空主機廠、知名汽車制造商等產業鏈上下游單位,開展深入合作,不斷推進創新鏈與產業鏈深度融合。
創新蝶變,“鋁”途輝煌。高端鋁合金型材制造大推力火箭可上九天探究蒼穹,建成萬噸巨輪可下五洋“對話”深海,制成高速動車組可與風競速……其價值比民用鋁合金產品翻一番。
“資源稟賦是科技創新的起跳板,科技創新是資源價值的放大器。”黃廷磊分析,廣西只要抓住地方特色資源發展經濟,不跟風隨大流,找出自己的優勢,咬定特色優勢領域和細分領域,不斷深耕,就大有可為。
二、現代產業是科技創新的主戰場
產業出題,科技答題。科技創新引領現代化產業體系建設。“首字號”科技創新成果的背后,藏著廣西產業發展的密碼。
例如,廣西是中國西南地區重要的汽車生產基地,柳州更是被稱為“中國汽車城”,擁有深厚的制造業積淀,為新能源汽車創新資源的高度集聚提供了沃土。
從2002年掛牌成立至今,上汽通用五菱汽車股份有限公司已累計申請2104件專利,成為首個達成“新能源汽車年產量突破80萬輛、累計產銷量突破3000萬輛”目標的中國品牌車企。

上汽通用五菱精益智造工廠。(上汽通用五菱供圖)
“我們領跑新能源汽車產業的底氣,來自強大的研發團隊和2022年3月組建的廣西首家自治區實驗室——廣西新能源汽車實驗室。”公司黨委書記、副總經理姚佐平介紹,依托實驗室,企業與8個院士團隊、重點高校、龍頭企業、檢測機構合作搭建科研團隊,為實驗室匯聚行業頂尖資源。在上海、武漢、長沙、深圳等地設立“人才飛地”,打通人才、技術、資金等創新要素的流通渠道。
西部陸海新通道骨干工程平陸運河的建設,也為智慧交通和工程領域的創新資源高度集聚提供了高能平臺。
今年初,全國首家運河實驗室——廣西現代運河實驗室揭牌成立。中國工程院院士、南京水利科學研究院總工程師胡亞安,受聘為實驗室首屆主任。該實驗室陣容強大,由平陸運河集團牽頭,聯合水利部、交通運輸部、國家能源局和南京水利科學研究院、廣西大學等多家單位共同建設。
胡亞安表示,實驗室力爭突破現代運河大型通航建筑物高效耐久建造、省水船閘服役狀態監測及運維等關鍵技術,推動大型現代運河理論研究和應用技術重大創新,力爭成為現代運河建設與運營標準制定者和技術引領者。
三、資源聚合是科技創新的魔術手
盤點多家“首字號”成果發現,其成功離不開政產學研用聯合,高能級創新平臺、人才以及持續加大研發投入,缺一不可。
“首字號”和一批高精尖成果的取得,與近年來廣西圍繞產業發展需求,有組織地開展重大科技專項行動,集中資源力量辦大事是分不開的。
2023年,廣西啟動首輪科技“尖鋒”行動,瞄準重點產業,聚合創新資源開展關鍵核心技術攻關。自治區科技廳相關負責人介紹:“尖是針尖,鋒是刀刃,把有限的科技資源集中到刀刃上,‘尖鋒’行動就是要強化統籌安排和組織實施,力求在較短時間內獲得關鍵核心技術突破,為高質量發展提供科技支撐。”
2024年底,首輪科技“尖鋒”行動順利收官,在新能源汽車、工程機械等7大領域累計組織實施重大項目220項,突破重大技術254項。
廣西玉柴機器股份有限公司的“黑燈工廠”就得益于科技“尖鋒”行動。“‘黑燈工廠’其實不黑,因為不需要人工操作、黑燈也能運行而得名。”玉柴公司精益改善總監王玉茂解釋,傳統需要100多人操作的車間,現在全部由機器人和自動化機床替代完成,效率提高90%以上。一臺發動機12小時就可實現合格生產并成功下線,生產周期縮短80%。

在玉柴“黑燈工廠”國六智能化生產線上,機器人正在作業。廣西玉柴機器集團有限公司供圖
據了解,玉柴目前已擁有玉林、南寧、無錫及歐洲四大研發中心,并建成一系列研發平臺,研發投入持續加大,強度超6%,其中玉柴國家企業技術中心評價位列全國第一,挺起了玉柴的創新“脊梁”。
新一輪科創,缺什么?
當前,新一輪科技革命和產業變革加速演進,科技創新促進產業發展的引領驅動作用更加凸顯。科技創新要發展好,有賴于創新生態的打造。“科技創新生態包括資金、人才、產業、創新平臺、政策、體制機制等要素。”不少業內人士坦言,廣西科技創新生態還要進一步優化提升。
一、缺資金——一邊民企融資難,一邊政府投資資金投不出
最新數據顯示,廣西的研發經費投入低于全國平均水平。企業研發投入較少,規上工業企業中有研發活動的占比僅12.1%,低于全國平均水平(30.7%)18.6個百分點;規上工業企業研發投入強度0.66%,僅占全國(1.55%)的四成。研發投入少導致企業科技創新能力不強,難以形成核心競爭力。
作為創新主體,企業為何研發投入較少?缺資金,融資難、融資成本高是主要原因。我們調研的區內科技企業紛紛表示,只要有資金,都愿意投入研發。但近年來企業營收銳減,普遍缺錢。“有限的資金首先用來保證企業存活,無暇顧及研發。”一位民營企業家說。
一些企業反映,他們向金融投資機構申請貸款很難。
南寧市一家工程設備龍頭企業負責人稱,即便公司已躋身行業一流,但想從金融機構獲得貸款也不容易。為此他們聯系政府投資基金管理部門,實際操作后發現,審批手續繁雜、周期長,算下來融資成本跟商業銀行一樣高。龍頭企業貸款尚且不易,眾多科技型中小企業融資難可想而知。
近期,一家冶金大企業因經費不足,暫停一項2000萬元的技改項目。企業表示,研發投入數額大,為了不影響企業的正常運行,幾經權衡,只能暫緩實施。
一邊是民企融資難、融資成本高,一邊卻是政府投資資金投不出。究其原因,主要在于有關部門要求投資資金必須保值增值。因為怕擔風險,所以政府投資部門顧慮重重、寧可不投。
風險投資體系是科技創新生態中非常重要的一塊。開年以來,像DeepSeek、宇樹科技等多家科技型中小企業引爆投資圈。據了解,這些企業大多在初創期都得到了杭州國有耐心資本的支持。
調研中,廣西本地企業都表示,比起錦上添花,更期望金融投資機構多些雪中送炭。南寧一家投資公司業務相關負責人則呼吁,科技創新產業化周期長、高投入、高風險,亟需耐心資本和長期資本的進入,同時配套相關風險擔保及稅收優惠政策,以此激勵社會資本投早、投小、投硬科技。
二、缺人才——高端人才難引進,本土培養難留住
有關統計數據顯示,廣西目前只有1名在職院士、2名資深(退休)院士,高端頂尖人才極度匱乏。
黃廷磊分析,廣西缺人才,原因有三:一是本地人才培養有限,大學數量少,只有1所雙一流高校;科研機構數量不多,難以滿足本地創新需求。二是廣西產業結構還比較單一,產業鏈短,中小企業多,薪資待遇偏低,客觀上也難以吸引和留住高端人才。三是由于產業承載力不夠強,尤其是高新技術產業較弱,本土培養的一些相關專業大學畢業生難留桂。根據桂林電子科技大學、賀州學院關于畢業生去向的調查顯示,人工智能、電子信息等專業畢業生,大部分選擇粵港澳大灣區等發達地區就業。
南寧漢和生物技術有限公司是全國生物合成領域的一流企業,產品暢銷歐美。即便如此,公司也招聘不到博士畢業生。為了吸引高端人才,公司打算在廣州建立研發分中心。無獨有偶,廣西多家實力企業同樣苦于吸引不到高端人才,早幾年就在北上廣深等大城市布局研發中心,或者成立“人才飛地”。
廣西產業技術研究院是自治區級新型研發機構,也同樣面臨招人難、留人難的問題。2024年,他們相繼設立長三角、大灣區創新中心,構建起人才技術雙核驅動的“科創飛地”,探索破局之道。
作為廣西科技創新主力軍和排頭兵的廣西科學院,近年來持續實施“桂科學者引才計劃”,柔性引進約200名高端人才,但仍滿足不了對人才的需求。為此,2024年,廣西科學院高新技術集團在香港設立人才飛地,打造人才小高地。
三、缺服務——扶持政策不多,服務意識不強
我們在調研中了解到,廣西一家移動破碎篩分設備領域龍頭企業,因為一個財務數據不達標,去年在國家級專精特新“小巨人”企業復核中沒有通過。
“受當前經營環境影響,公司營業收入減半,在這樣的情況下,我們仍咬牙堅持增加研發投入,就因深知技術創新是企業生存和發展之本。公司的研發投入占營收的6%—7%,遠高于行業平均水平。”談起被“摘帽”的事情,企業負責人滿肚子委屈。他告訴我們,企業的技術在全國領先,“如果有關部門在同等條件下給予一些扶持,我們的財務數據可能就達標了。”
廣西一位甘蔗育種領域的專家也感觸頗深。40年來,他先后育成5個甘蔗新品種并登記審定,但苦于沒有推廣專項經費,新品種的推廣速度比較慢。
“我們了解糖業相關補助政策的渠道太少,難以爭取到相應的經費。”該專家說,國外的一些做法值得借鑒,比如澳大利亞對甘蔗新品種推廣有專項補貼,對有推廣潛力的新品種,糖廠、行業協會還會聯合補助經費。
近期,網上流傳一條頗受民企關注的短視頻——浙江杭州一家科技型企業,按照當地有關規定網上申報創新創業專項資金補助,全程沒跟業務部門工作人員見面,經過在線審批,幾天后補助資金直接轉到企業賬戶。高效便捷的辦事效率讓企業主連連點贊。
調研過程中,廣西不少企業向我們反饋,申請政府有關專項補助比較麻煩,周期長,有的甚至申請獲批后2年才發放。
南寧一家專精特新“小巨人”企業負責人,將廣西和長沙招商引資的做法作了比較。“公司躋身行業龍頭企業后,長沙市有關部門主動找來,以一企一議的方式誠邀我們去長沙落戶。去年,公司去上海參加展會,他們為了跟我們面談,就我們的時間一直等到晚上10點。”他認為,廣西的招商思路可以更靈活些。
“近段時間,大家都討論為什么‘六小龍’會出現在杭州,這與當地政府主動服務意識有很大關系,做到了‘無事不擾,有事必到’,給予企業充足的發展空間。”廣西產業技術研究院科技開發部部長王英輝說。
廣西一高新技術企業負責人李女士投資1200多萬元,并多方籌措經費,成功研發專利產品——中央空調節能降耗技術和設備,在中央空調領域全國領先。之后,她一直在為技術融資貸款奔忙。經多方推薦,2021年,一家國有投資公司看中了該技術,按照程序安排第三方機構來進行技術評估。“沒想到評估人員只有1人,而且是外行,難以給出專業意見,融資的事情就此擱淺。”李女士說,之前她在廣東創業,接觸到的投資公司,但凡有中意的項目,會選派一個專業機構或團隊全方位對技術項目進行評估,嚴謹負責。“評估過程不專業,折射出有關部門亟需提升主動服務意識。”李女士說。
差異化發展,怎么走?
一、錨定方向
推進高質量發展,同質化競爭沒有出路,必須堅持差異化發展,才能闖出新天地。要走差異化競爭之路,選準方向是第一步。
1.以“一子落地滿盤活”的決心,全面擁抱人工智能
人工智能是引領新一輪科技革命和產業變革的重要驅動力,發展人工智能,是大勢所趨。廣西能否迎頭趕上?
今年爆火的電影《哪吒2》,讓人們看到了貴州強大的算力能力。同為西部省區,貴州有何經驗?帶著問題,調研組前去尋求“他山之石”。
2015年,中國第一個國家數據中心——備災中心落地貴州貴安新區,拉開貴州算力基建大幕。彼時外界質疑:“偏遠山區搞數據中心?”對此,貴州堅定發展信心,立足氣候、能源、地質條件等優勢,深耕10年,成為全國智算資源最多、能力最強的地區之一,全省人工智能大模型已應用在輪胎、電力、化工等50多個場景。

貴州給我們的啟示:只要敢想敢干,動腦筋地干,欠發達地區一樣可以走出一條具有自身特色的人工智能產業發展之路。圖為貴州貴安超級計算機中心機房。(貴州日報供圖)
數實結合怎么做?貴州貴安發展集團副總經理申亞柳,介紹了集團如何通過“算力+產業”,實現從“搞基建的土包子”向高科技轉型。作為國家級新區貴安新區產城融合的投資商、運營商、服務商,貴安集團依托“東數西算算力產業集群”“超互聯新算力基礎設施”兩大項目,一方面打造集算、數、網、云、端、模為一體的大數據產業基礎設施,一方面構建智慧城市應用場景。
“項目實施之前,貴安新區雖然有大數據企業及數據中心,但真正用于產業的還很少。”申亞柳告訴記者,他們一邊做一邊完善規劃,干起來再說。通過一步步與華為、科大訊飛等頭部企業合作,帶動更多算力產業上下游企業在貴安新區孕育、匯聚,形成產業生態。
貴州給我們啟示:只要敢想敢干,動腦筋地干,欠發達地區一樣可以走出一條具有自身特色的人工智能產業發展之路,廣西要有信心。
今年全國兩會,政府工作報告提出要持續推進“人工智能+”行動。此前廣西“新春第一會”也強調以人工智能賦能千行百業。這說明,推動人工智能和實體經濟不斷融合,是大勢所趨。
當前,廣西成立由自治區黨政主要領導為組長的人工智能發展工作專班,實施中國工程院戰略咨詢項目《面向東盟的廣西人工智能應用戰略研究》,優化頂層規劃設計。政府部門、高校、企業等紛紛開始行動,布局“人工智能+”。自治區工信廳提出,力爭到2027年形成100個標志性智能產品,打造100個人工智能典型應用場景;自治區科技廳聚焦林業、糖業、工程機械、有色金屬、交通物流、口岸貿易等,啟動一批人工智能行業垂直領域應用研發項目,力爭培育2—3個有全國競爭力的行業大模型;并實施賦能行動,聚焦典型應用場景,支持一批大模型示范應用項目。
廣西科學院院長元昌安認為,做大模型不能急功近利,要真正解決行業的痛點堵點。廣西在人工智能應用領域應做到“人無我有,人有我用,突出特色,錯位發展”,在智慧農業、智慧海洋、智慧旅游、智慧物流等廣西特色急需的方面,開展人工智能技術的研究和大規模應用。
2.以“咬定青山不放松”的恒心,持續深耕實體經濟
實體經濟是國民經濟的根基,只有牢牢守住這個根基,才能為產業創新提供堅實支撐。盤點廣西經濟基本盤,傳統產業占全區規模以上工業增加值近80%,這是廣西的家底,也是優勢。同時,廣西不少傳統產業,還處在只有“灌木林”,或者“見木不見林”的階段。面對這種現狀,當務之急不是另起爐灶,而是更應重視深耕已有產業,爭取“育苗成林”。
漢和生物董事長梁承介紹,漢和以廢棄生物質為原料培養微生物,研發功能性氨基酸、功能性糖等創新產品。公司的生物制品廣泛使用于藥品、保健品、食品、護膚品、新型肥料等產品之中。“我們的產品供不應求,今年的任務是擴產再擴產。”梁承自信地說。
廣西是農林大區,秸稈等廢棄生物質資源十分豐富,但由于產業鏈短,目前大多只能進行低值利用,甚至丟棄。漢和從事的合成生物產業,通過創新技術對廢棄生物質進行高值化利用,恰好是對農林產業鏈條的延伸和升級。目前,廣西產研院、南寧市高新區正積極與漢和合作,謀劃以龍頭帶動,推動合成生物這一新興產業在廣西的發展。
漢和的例子說明,產業發展的過程,蘊藏著無數創新的需求和機會。今年廣西提出,立足產業基礎和資源稟賦,深入實施優勢產業“串珠成鏈”行動和先進制造業集群培育行動,繪制12個自治區級先進制造業集群的技術創新和產業發展路線圖,表明了持續深耕實體經濟、以產業升級鍛造新質生產力的決心。
二、集中發力
科技創新是一項全局性、綜合性的系統工程,需要強有力的組織保障和政策支持,才能更好地統籌資源,集中發力。
2024年,自治區黨委科技委成立,實現科技領導和管理體制的系統性重構、整體性重塑,構建起協同高效的決策指揮體系和組織實施體系。今年,廣西將進一步推動出臺加快建設高水平創新型廣西實施意見,做好頂層設計和總體謀劃,對今后一個時期的科技創新進行系統部署。
1.不撒胡椒面,提高組織科技創新的效率
科技創新需要人、財、物等大量資源投入,廣西資源有限,更要用在刀刃上。有組織的科研通過科學管理實現資源有效利用,是提高科技創新活動效率的重要途徑。但是,當前廣西還存在面向產業高質量發展的有組織科研攻關不夠、組織效率不高、過程簡單化等問題。
如何讓科研活動更精準高效?柳州市在全區率先探索“有組織有條件的科研”模式,較好解決了科研項目小而散、經費“撒胡椒面”和虛假包裝項目等問題。
柳州市科技局局長管偉榮介紹,過去申報科研項目主要是企業提出攻關方向、課題,科技主管部門批準、立項。這種自下而上的方式,容易導致科研攻關只從企業出發,沒有站在國家、自治區層面和整個產業發展的大方向考量。為此,柳州市科技局主動作為,在征集企業需求的基礎上,根據城市發展、產業發展的要求去引導、布局科研項目,形成上下結合凝練科技任務的機制,提升科研項目的質量。
在此基礎上,柳州市進一步組織龍頭企業和有較強科研能力的企業,協同高校、科研院所、產業鏈上下游企業和創新鏈企業,共同承接國家、區市的科技項目,形成創新合力,提高攻關成效。
在提高科研經費利用效率方面,柳州市采取“有條件的科研”方式,規定企業申報項目必須具備相應的科研能力,并在經費投入、人才儲備、設施設備、研發平臺等方面設置了“九有”條件,確保把錢投給在科研方面真投入、大投入、長期投入的企業。在實施項目時,采取“前補助、后補助、里程碑式階段性補助”等撥付方式,使經費得到有效使用。
2.加強產學研協同,形成創新合力
高校、企業、科研院所是科技創新的主力。杭州“六小龍”橫空出世,浙江大學等高校提供的技術、人才支持功不可沒。我們通過調研感受到,廣西在產學研協同方面還存在淺層化、碎片化的現象,缺乏長期規劃與系統性整合,合作成果難以形成持續競爭力等問題。
一方面,科研和產業需求脫節的現象仍然存在。王英輝在進入廣西產研院之前,長期在高校工作,對產研“兩張皮”的現象深有體會:“在高校做科研,有時候只是為了做課題、發論文、評職稱,不面向經濟主戰場,就像坐井觀天,圍繞自己研究的一小塊領域、一個小圈子,跟企業對不上話。”
另一方面,廣西工業企業規模普遍偏小,中小企業研發能力薄弱,吸收科研成果的二次研發能力欠缺,與高校、科研機構的合作停留于低層次,也是導致科研成果難以落地的重要原因。
如何破解技術攻關“孤軍奮戰”、科研成果“孤芳自賞”等問題?
一是打造高水平創新平臺。以產學研創新聯合體、新型實驗室、新型研發機構為載體,集聚各類創新要素,建立以企業為主體、市場為導向、產學研深度融合的技術創新體系。去年,廣西共認定17家自治區新型研發機構、9家自治區創新聯合體、13家自治區級科技創新合作基地,今年還將組建7家創新聯合體、16家新型研發機構。
二是強化企業的創新主體地位。管偉榮介紹,柳州規定,所有科研項目都以企業為主來申報,“企業跟高校或科研機構合作申報項目,必須是為解決企業面臨的問題,而不是僅為了高校評職稱等。我們90%以上的項目、資金,都是給工業企業,脫離企業需求的我們不支持”。
自治區科技廳有關負責人表示,今年將采取具體措施進一步加大企業參與科技創新的力度,包括支持企業參與科技項目指南編制,將企業評審委員占比提高到1/3以上;支持企業主導產學研合作,將企業牽頭實施的產業類科技計劃項目比例提高到70%以上;探索“鏈主企業聯合出資掛榜”,攻關產業共性關鍵技術;將企業出資且符合要求的科技項目納入自治區科技計劃項目;建立企業參與項目驗收評價機制。
三是健全教育科技人才一體發展工作機制。推動出臺《廣西教育科技人才支撐現代化產業發展三年行動方案(2024—2026年)》《關于加快構建現代化產業體系人才引領支撐的若干措施》等政策文件,暢通教育、科技、人才的良性循環,助力創新鏈產業鏈資金鏈人才鏈深度融合。
三、久久為功
發展緊迫感帶來的“風口焦慮”很容易讓人忘記,創新需要厚積薄發。因此,我們必須時刻提醒自己,不要急功近利,要久久為功。
1.立足當前,著眼長遠
杭州以“包容十年不鳴,靜待一鳴驚人”的定力和耐心孵化出“六小龍”,而廣西產研院關于“兩條路徑”的探索,也印證了“干事業就像打油茶,火候到了自然香”的規律。
廣西產研院是自治區成立的新型研發機構,擁有自建及合作專業研究所26家。成立產研院的目的,一是為廣西重點產業服務,瞄準“卡脖子”技術,組織力量攻關;二是破解產研“兩張皮”,探索以靈活機制加速科研成果轉化。
“5年前成立之初,對于新型科研院所怎么定位,是做科研型的企業,還是企業型的科研院所?大家都有些拿不準。”廣西產研院輪值院長唐亮東回憶。
企業的目標是效益、是盈利,而研發機構要產人才、產成果、產技術,設定考核指標,到底以何為主,怎么平衡?“我們一所一策,允許大家試,三五年見分曉。”唐亮東說。
探索過程走過彎路,也有成功經驗,不同的路徑導出了不同結果。個別所急于求成,不在研發技術儲備上下功夫,直接加入短期市場,跟中小企業競爭。“總想著賺錢,就影響科研思路。這樣即使一時賺到錢,又有何意義?”唐亮東表示。
一些研究所不計一時得失,堅持瞄準產業共性問題鉆下去。以產研院人工智能與大數據應用研究所為例,成立伊始即前瞻性布局人工智能領域,經過5年默默耕耘,培育了一支具備人工智能全棧開發能力的人才團隊,在冶金、汽車、機械、電力、旅游等領域構建了多個典型AI應用場景,在多個領域初步實現人工智能的內核嵌入,構建起一批高質量數據集;服務數十家廣西重點行業龍頭企業及超過1000家中小企業,成為廣西人工智能賦能產業發展的一支主力軍。
另一家研究所——功能材料所,對“兩條路徑”也有深刻體會。所長黃科林告訴調研組,功能材料所頭4年有3年在虧損,經營考核指標為0分。一開始,為了完成營收指標,所里還做過貿易,不過很快就停止了,把注意力集中在了材料產業關鍵核心技術研發上。
經過努力,去年功能材料所在省部級科學技術獎一等獎、牽頭承擔重大專項、參與制定國家標準、牽頭組建省級工程研究中心及培育規上企業等五個方面實現零的突破,并通過成果轉化反哺科研。
2.優化生態,陽光雨露
今年杭州“六小龍”出圈,帶火了“生態”一詞。一個地方創新生態的豐富性,決定其發展高度。杭州的經濟體量、人才資本、產業基礎等硬條件,廣西比不上,但是打造生態的底層邏輯是相通的。杭州的“我負責陽光雨露、你負責茁壯成長”的服務意識、“從6000個龍蛋中孵6條真龍”的容錯意識,正是廣西當下所缺。
以政策服務為例,廣西的政策資源不少,要用足用好,就要讓創新主體充分了解政策、更容易享受政策紅利。調研中,一家科研單位的負責人感嘆:“我在政府部門工作多年,現在到科研單位,想了解某些產業政策或規定時,也不知道能去哪里找。”
與此形成對照的,是貴州依托數字技術在全國首創的企業綜合服務平臺“貴商易”。借助智能算法,平臺自動篩選符合條件的企業,精準推送政策條款、產業扶持等信息,幫助企業申請獎補、貸款等,讓“政策找企業更準、企業找政策更易”。
又以構建容錯環境為例。資金扶持是科創項目穿越發展“死亡谷”的重要助力,而厭惡風險又是資本市場的顯著特征。解開這一兩難困境的鑰匙,就是設立容錯機制。盡管這一觀念已經成為共識,但在實踐過程中遲遲沒落實,這使得“耐心資本”在廣西還很弱,無法為創新提供支撐。
南寧一家投資公司業內人士表示,政府科創投資基金是耐心資本的重要引領力量,要推動對國資創投的考核指標從保值增值優先向創新優先轉變,同時要健全財政、金融、國資監管、審計、稅收等部門間的跨部門協調機制,減少容錯機制政策理解偏差與執行沖突。
3.主動作為,提升本領
政府在創新生態的構建中發揮著重要作用,服務不完善也好,沒有容錯環境也好,究其原因,跟政府部門和干部是否主動擔當作為,以及干事創業的本領是否足夠有關。
調研中,一位科研單位的專家說,他們曾就糖業一產、二產的創新發展提出一系列解決方案,并提供給有關部門,結果沒得到太多回應。“科研創新對我們來說是全部,但對政府主管部門來說,只是眾多工作中的一項。是否能統籌做好各項工作,是對有關部門及領導干部‘十個指頭彈鋼琴’能力的考驗。”
針對有的部門服務意識不強,不同程度存在“甲方”思維和“衙門作風”的問題,廣西“新春第一會”提出,要帶頭轉變作風,切實提高服務基層的能力和本領;要對自治區有關職能部門開展測評,讓習慣當“甲方”的部門緊張起來……這系列舉措的目的,就是要讓實干成為廣西干部身上最鮮明的特征。
四、開放帶動
廣西創新基礎薄弱,必須走借梯登高、借力發展的開放帶動之路。廣西區位優勢明顯,通過擴大高水平對內對外開放,加速資源整合、技術協同、人才互通,可以有效帶動科技創新和產業創新。
1.建設面向東盟的科技創新合作區,助力人工智能等先進技術在廣西匯聚轉化
走進潤建股份有限公司南寧五象云谷智算中心,機房內成群的機柜整齊排列,指示燈閃爍跳動。
“依靠強大的算力,我們積極布局面向東盟的人工智能業務,目前與馬來西亞教育部門合作,開發了職業院校AI專業課程體系、共建AI實訓實驗室等數字化教育方案,實現廣西的大模型能力和產品輸出東盟國家。”潤建股份人工智能事業部總經理丁永說。據了解,去年五象云谷智算中心面向東盟的數字項目銷售額達1.2億元。
潤建股份是廣西人工智能技術出海的一個縮影。找準賽道和切口,面向東盟發展人工智能,就是廣西的獨特優勢。廣西與東盟地緣相連,積累了語料基礎、語言人才等一系列優勢,將成為中國人工智能技術走向東盟的“第一站”。
在十四屆全國人大三次會議上,廣西代表團提交了《關于支持廣西設立中國—東盟人工智能創新合作中心的建議》。抓住中國人工智能技術出海的機遇,以建設創新合作中心為切入點,吸引一批國內人工智能頭部企業和東盟國家人工智能企業到南寧設立研發中心,在輻射東盟的同時,也帶動國內人工智能領域的先進技術、企業、人才在廣西集聚,提升廣西的人工智能產業發展水平。
按照國家區域科技創新布局,廣西要建設面向東盟的科技創新合作區。今年,除了推動中國—東盟人工智能創新合作中心建設之外,廣西還將面向東盟國家提供30項先進適用技術,爭創1家“一帶一路”聯合實驗室,面向東盟實施10個以上示范性、帶動性強的國際科技合作項目等。
專家認為,要發揮廣西區位優勢,以開展人工智能技術創新合作為引領,構建“技術研發—產業應用—人才支撐—國際輻射”的鏈條,使廣西成為中國技術出海的一個重要樞紐和中轉站。在此過程中,帶動更多前沿技術的研發創新在廣西落地,是加速科技和產業創新的有效途徑。
調研中我們也了解到,開展與東盟的技術合作,還面臨著一系列挑戰。以人工智能為例,在低成本算力資源、公共數據開放共享、人才培養引進等方面都還存在堵點。中國—東盟信息港股份有限公司總裁助理李昌金介紹,開發人工智能產品過程中,高昂的算力成本成為企業較大負擔。桂林電子科技大學校長助理孫希延表示,人工智能是新興領域,要注意數據跨境流動、安全隱私等方面的問題;另外,還需要加大資金投入,可以從一些專項資金或基金里設立切塊資金,支持面向東盟的人工智能合作。
2.深化科技開放合作,實現借力發展
缺錢、缺人、缺技術,一直是廣西創新發展中的老大難問題。5年前,廣西科學院也面臨這樣的問題。怎么辦?科學院轉變思路,走開放辦院的路子,不搞內設機構,而是與社會力量合作。他們每年投入5000萬元資金引進區內外優秀人才,聯合建設新型研發機構。
“開放辦院集聚了人才,擴充了科學院的力量。”元昌安介紹,原來科學院的研究力量只有三個領域:生物技術、植物保護和利用、海洋研究,通過開放辦院,新增了人工智能等當前廣西經濟建設急需的五大領域,新引進200名博士等高端人才,有效支撐廣西經濟主戰場。
廣西科學院的探索說明,面對“三缺”的結構性矛盾,廣西很難靠一己之力解決,必須主動利用各種資源,尤其是積極融入國內外創新網絡,通過擴大科技開放合作,吸納和集聚更多創新要素,實現借力發展。
深化科技開放合作,首先要立足產業,圍繞產業轉型引發的科技需求,內引外聯,構建系列創新合作機制,廣泛匯聚國內外科技創新力量。
當前,國家高度重視區域創新的整體性和一體化,廣西要善用區位優勢,積極加強與發達地區的產業對接合作。比如在人工智能產業方面,直接切入東部發達地區人工智能產業鏈,重點發展智能機器人零部件、專用傳感器、智能儀器儀表等智能終端產業。
共建共享創新平臺,是跨區域科技合作實現互利共贏的重要抓手。要充分利用好廣西(上海、深圳)產業合作中心等重大平臺,持續加強與大院大所交流合作;同時,創新合作體制機制,不求我有、但求我用,積極在發達地區設置科創“飛地”,用好用活國家布局在發達地區的重點實驗室、大科學裝置、實驗資源、創新創業空間等各類平臺;“走出去”的同時還要“引進來”,積極引進高水平科研院所、研究型大學設立新型研發機構,讓高水平創新平臺和資源更好地為廣西科技發展服務。
人才是科技開放合作的重要內容。近年來,自治區科技廳通過“帶土移植”“厚土培植”等創新舉措,引育了一批創新發展急需的高層次人才,人才引進工作取得一定成效。同時,調研中專家也提醒,人才引進不能只看名氣,只為了增加知名度或者完成某項指標。據了解,當前廣西有不少人才是依托高校引進,主要是學術人才,不是產業人才,在今后人才引育中,要注意引進更多的產業人才,真正為經濟主戰場服務。
